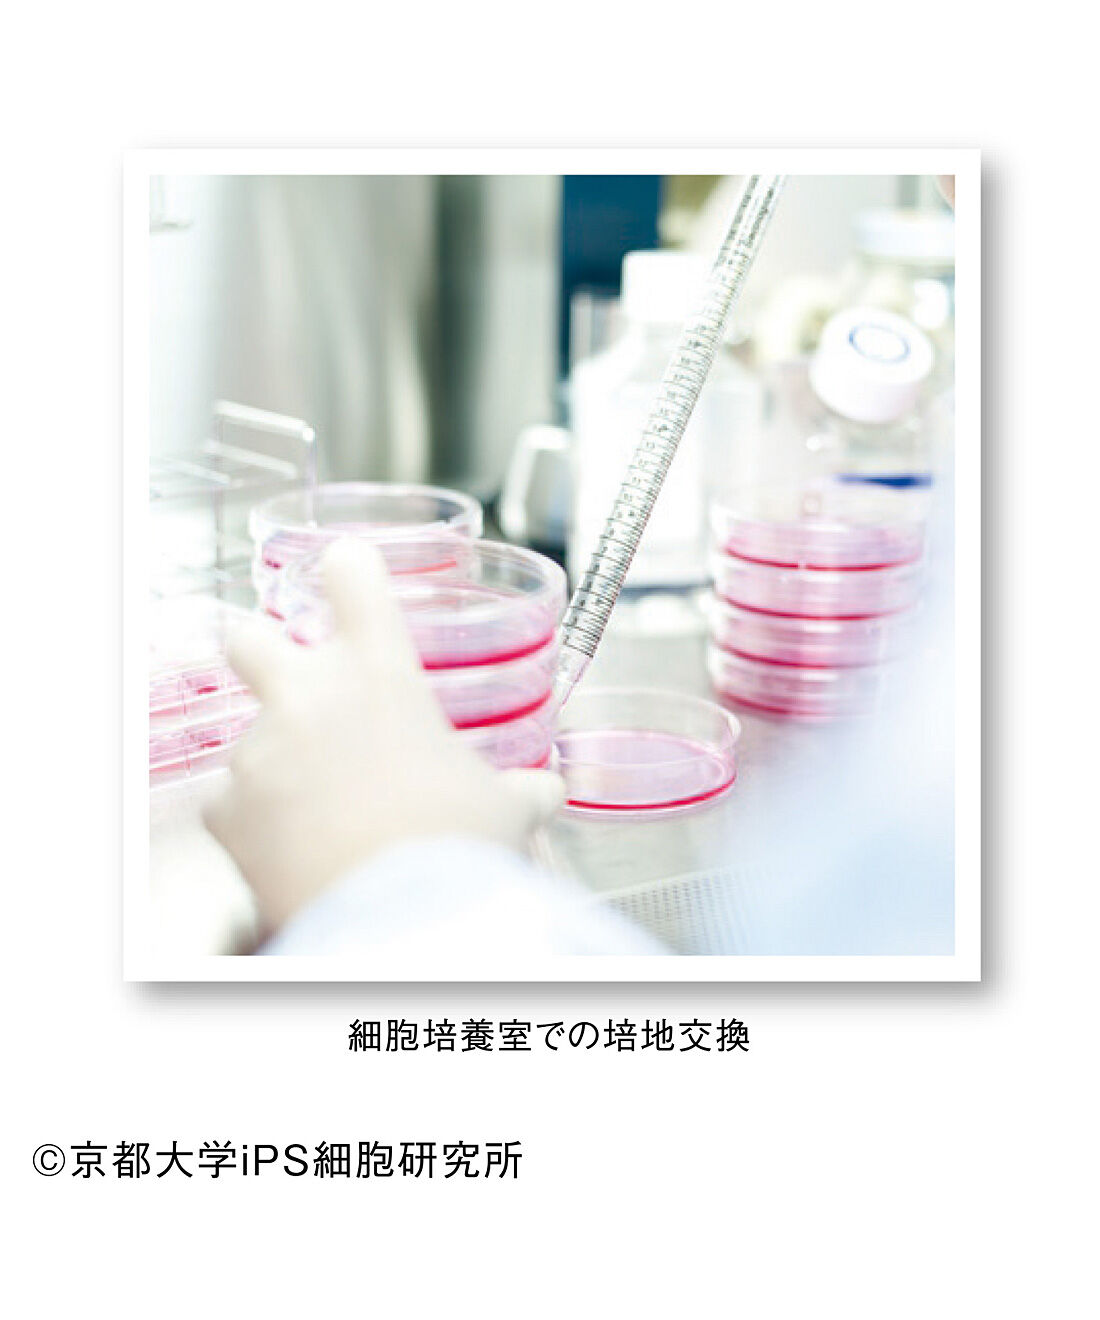

みなさまへのメッセージ
平素はiPS細胞研究にご理解を賜り、ありがとうございます。たくさんの方々のご支援に支えられてiPS細胞研究を続けられますことに、心から感謝申し上げます。iPS細胞は再生医療や新しい薬の開発を実現するために重要な役割を果たすと期待されています。今は有効な治療法がない病気やケガにiPS細胞を使って、新しい治療を実現することを目指して研究を進めております。みなさまからのご支援は、医療応用や研究費の支援、次世代を担う優秀な研究者の積極的な登用や育成、知財の確保・維持の費用などに大切に使わせていただきます。患者さんや周りで支えておられる方々へ、一日も早くiPS細胞による医療をお届けするために、あたたかいご支援を賜りますよう、よろしくお願い申し上げます。
(iPS細胞研究所 所長 髙橋 淳)

活動の現場から
iPS細胞技術と免疫治療が融合した「がん免疫再生療法」 がんの治療法に、免疫細胞を活性化させてがん細胞を攻撃する「免疫療法」があります。京都大学iPS細胞研究所ではこの免疫療法とiPS細胞技術を組み合わせた「がん免疫再生療法」の研究を進めています。免疫細胞には、細菌やウイルスなどの病原体や異物を攻撃するT細胞やNK細胞があり、がん細胞を狙って攻撃する能力を高めたこれらの免疫細胞をiPS細胞から作製し、患者さんに投与する治療法です。2021年4月から国立がん研究センター東病院と協力し、卵巣がん治療に対する臨床試験が開始されました。今後はさまざまながんや免疫疾患などがん以外の病気の治療への応用も目指しています。